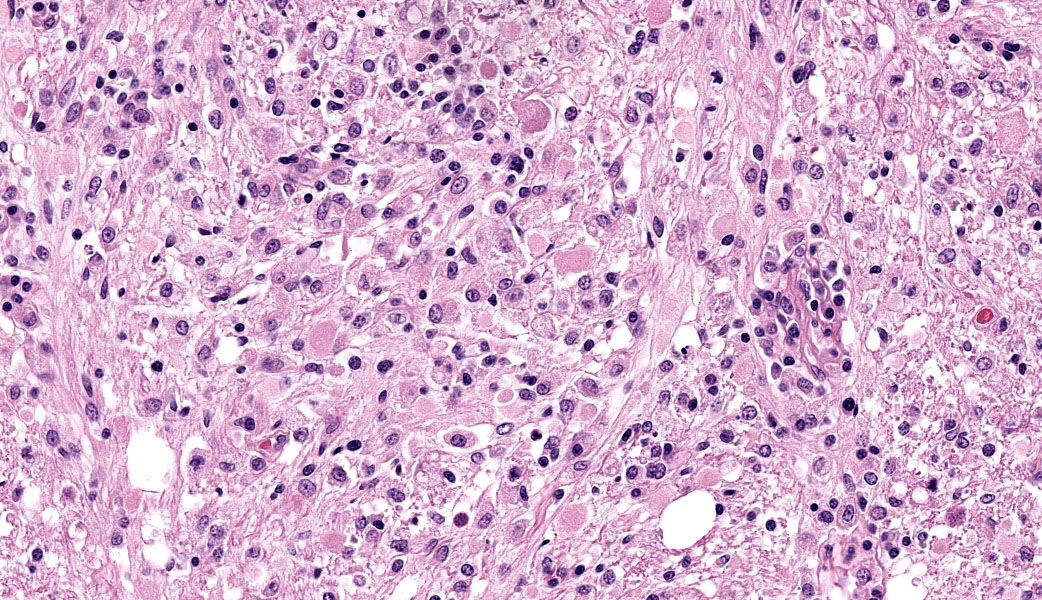

Conference 18, Case 3
Signalment:
1-year-old, intact female, pit bull (Canis familiaris)
History:
History of weight loss despite appetite and diarrhea. Animal became neurologic and blind for approximately one week until developing seizures. No reported bloodwork abnormalities (complete blood count, blood serum chemistry, and bile acids). Dog was euthanized and submitted for necropsy.
Gross Pathology:
The animal was emaciated with generalized muscle atrophy and scant visceral adipose. The pancreas was reduced to small, thin, red-grey lobules. In the small intestine, there was mild ancylostomiasis with segmental intraluminal hemorrhage. The feces in the distal colon were pale green and soft. The lateral ventricles of the brain were mildly dilated.
Laboratory Results:
- Toxoplasma gondii PCR: positive (CT brain: 25.4, heart: 21.4)
- Neospora caninum PCR: not detected
- Fecal testing: Ancylostoma ova detected
Microscopic Description:
Brain: The meninges are moderately expanded by macrophages, plasma cells, and lymphocytes that surround and partially obscure reactive meningeal vessels. Inflammatory cells extend around vessels into the subtending parenchyma, filling and expanding Virchow Robin spaces up to 12-15 cell layers thick. There are focal areas of infiltration of macrophages, lymphocytes, and plasma cells into the surrounding parenchyma with associated vacuolation and necrosis of the parenchyma, neuronal satellitosis and necrosis, infiltration of gitter cells, gliosis, and astrocytosis. Isolated within the parenchyma and associated with areas of inflammation and necrosis are numerous 12 to 45-µm diameter protozoal cysts containing closely packed clusters of 1 to 2-µm wide, crescent-shaped bradyzoites. At the level of the corpus striatum, there is vacuolation of white matter tracts with occasional spheroids, digestion chambers, and numerous protozoa. Vessels adjacent to the lateral ventricle are obscured by macrophages, lymphocytes, plasma cells, and neutrophils with indistinct, hypereosinophilic vascular walls (necrosis) and perivascular exudation of fibrin and edema. The ependyma spanning the lateral ventricle is segmentally discontinuous with disruption by inflammatory cells and necrotic material that extend into the ventricular lumen.
Contributor’s Morphologic Diagnoses:
Brain: Meningoencephalitis and ventriculitis, necrotizing and histiocytic to lymphoplasmacytic, subacute, multifocal, moderate, with protozoal cysts and zoites, vasculitis and vascular necrosis.
Contributor’s Comment:
Toxoplasmosis is caused by the apicomplexan protozoan Toxoplasma gondii.4 It can infect a variety of hosts including mammals and birds and causes a wide spectrum of disease.3,4 Toxoplasmosis is an important zoonotic pathogen and cause of abortion in primates, prosimians, and ruminants.6,7
Infected felines may serve as definitive or intermediate hosts, while all other non-felids act as intermediate hosts.3,4,7 In felines, enteroepithelial replication culminates in the release of unsporulated oocysts in the feces, which sporulate in the environment and become a source of infection for both definitive and intermediate hosts.4,7 Oocysts are only produced in the definitive felid host.3,4 Infection of intermediate hosts follows an extraintestinal replication cycle with rapid division of tachyzoites spread widely throughout multiple tissues.6 A third infective form involves the deposition of latent tissue cysts in tissues containing slowly replicating bradyzoites.3,4 Infection occurs following ingestion of sporulated oocysts shed from definitive host in the environment or via consumption of zoites or tissue cysts from infected prey. Alternatively, infection can occur transplacentally.3
Manifestation of clinical disease may vary given the wide distribution of protozoa within tissues. Systemic disease is classically characterized by interstitial pneumonia, hepatic necrosis, lymphadenitis, myocarditis, and meningoencephalitis.7 Other lesions may include uveitis, adrenalitis, nephritis, myositis, and placental necrosis/placentitis.3
Central nervous system disease is more common in young or immunosuppressed individuals and is difficult to differentiate histologically from Neospora caninum, Sarcocystis spp., or Encephalitozoon cuniculi, thus requiring additional testing modalities (immunohistochemistry, PCR, and/or special histochemical staining) to differentiate.4 However, observing necrosis in multiple organ systems associated with the presence of protozoal infective stages is most suggestive of toxoplasmosis.7
In dogs, toxoplasmosis is rarely a primary disease and often seen in conjunction with immunosuppression or comorbidities.2 Immunosuppression was suspected in this dog. Although clinical data (i.e. serum trypsin-line immunereactivity) supportive of exocrine pancreatic insufficiency (EPI) was not available, the reported clinical signs of diarrhea and weight loss despite sufficient appetite are suggestive of EPI. This is further supported by postmortem lesions of pancreatic atrophy, pale stools, and emaciation. It is possible that EPI resulted in immunosuppression from chronic malnutrition, nutrient deficiency, and possible cobalamin deficiency from small intestinal bacterial overgrowth (SIBO). These factors may have predisposed this dog to the development of systemic toxoplasmosis.
Contributing Institution:
University of Georgia College of Veterinary Medicine
Department of Pathology
Tifton Veterinary Diagnostic and Investigational Laboratory
Tifton, Georgia, USA
www.vet.uga.edu/dlab
JPC Diagnoses:
Cerebrum: Meningoencephalitis, necrotizing and lymphohistiocytic, subacute, multifocal to coalescing, marked, with vasculitis and apicomplexan cysts.
JPC Comment:
A classic and oft-seen entity in the WSC, Toxoplasma gondii makes another appearance this year in a fantastic canine case. Organisms were readily apparent within the neuropil of the periventricular grey matter on the H&E slide, prompting an excellent discussion of T. gondii and the zoonotic risk these infections pose. The contributor provided an excellent comment in this case and, once again, many of their points were mentioned in conference discussion.
Toxoplasma gondii is an obligate intracellular apicomplexan protozoal parasite that was named in 1908 by researchers Nicolle and Manceaux.1 They the names comes from the Greek word “toxon” (meaning “bow” or “arc”), referring to the crescentic shape of the tachyzoite stage, and “gondii”, chosen in honor of the North African gundi (Ctenodactylus gundi). This rodent is the host animal in which the parasite was first identified.1 Since its initial discovery in the gundi, T. gondii has been identified in numerous mammalian species and in a wide range of tissue types.
The pathogenesis of T. gondii starts with penetration of the intestinal mucosa by a tachyzoite, sporozoite, or bradyzoite either from ingestion of an infected host, from transplacental transmission, or by consumption of oocysts from the environment. The zoites can then either be trafficked in leukocytes to other tissues (i.e., lymph nodes and liver) or remain free in the bloodstream. The tachyzoites replicate within host cells until the cell lyses, at which point the tachyzoites are free to infect other cells and cause additional tissue damage. Cell-mediated immunity eventually can control, but not eliminate, the infection, and the parasites form dormant tissue cysts filled with bradyzoites within the heart, skeletal muscle, and brain in the chronic stages of infection.
Systemic toxoplasmosis is seen predominantly in neonates that were infected transplacentally or in immunocompromised animals that have low levels of interferon gamma and an inability to activate macrophages. In systemic “toxo”, the hallmarks of infection include necrosis and the presence of zoites. These most often manifest as either interstitial pneumonia (most common), meningoencephalitis (with necrosis, malacia, vasculitis, and vascular necrosis), focal hepatic necrosis, lymphadenitis, and/or myocarditis.
In cases of meningoencephalitis, the parasites can enter the brain by breaching the blood–brain barrier (BBB) using three possible mechanisms: 1) infection of monocytes that then traverse the endothelium, 2) direct penetration and migration across the BBB, or 3) infection of and growth within endothelial cells and eventual exit into the neuropil.5 Once inside the brain, T. gondii can infect multiple cell types, including astrocytes, microglia, and neurons, and form tissue cysts.5
Although not present in the examined slide in this case, the contributor mentioned that this dog also had histologic and gross evidence of pancreatic atrophy and atrophic lymphocytic pancreatitis. In dogs, juvenile pancreatic atrophy is an immune-mediated condition characterized by infiltration of T-cells (predominantly CD8+) into the pancreas.2 Around 6-12mo of age, affected dogs start to demonstrate clinical signs of exocrine pancreatic insufficiency. Histologically, pancreatic ducts and connective tissue structures predominate in the later stages of this condition with fatty replacement and minimal exocrine tissue, little inflammation, and fibrosis.2 Participants speculated on and agree with the contributor that the exocrine pancreatic insufficiency suspected in this dog may have led to immunocompromise and subsequent systemic toxoplasmosis infection.
References:
- Black MW, Boothroyd JC. Lytic cycle of Toxoplasma gondii. Microbiol Mol Biol Rev. 2000;64(3):607-623.
- Brenner K, Harkin KR, Andrews GA, Kennedy G. Juvenile pancreatic atrophy in Greyhounds: 12 cases (1995-2000). J Vet Intern Med. 2009;23(1):67-71.
- Calero-Bernal R, Gennari SM. Clinical toxoplasmosis in dogs and cats: an update. Front Vet Sci. 2019;6:54.
- Cantile C, Youssef S. Nervous System. In: Maxie MG, ed. Jubb, Kennedy, and Palmer’s Pathology of Domestic Animals. Vol. 1. 6th St. Louise, MO: Elsevier; 2016:387-389.
- Courret N, Darche S, Sonigo P, Milon G, Buzoni-Gâtel D, Tardieux I. CD11c- and CD11b-expressing mouse leukocytes transport single Toxoplasma gondii tachyzoites to the brain. Blood. 2006;107(1):309-316.
- McAloose D, Stalis IH. Prosimians. In: Terio KA, McAloose D, St. Leger J, eds. Pathology of Wildlife and Zoo Animals. San Diego, CA: Elsevier; 2018: 338.
- Uzal FA, Plattner BL, Hostetter JM. Alimentary system. In: Maxie MG, ed. Jubb, Kennedy, and Palmer’s Pathology of Domestic Animals. Vol. 2. 6th St. Louise, MO: Elsevier; 2016:236-238.